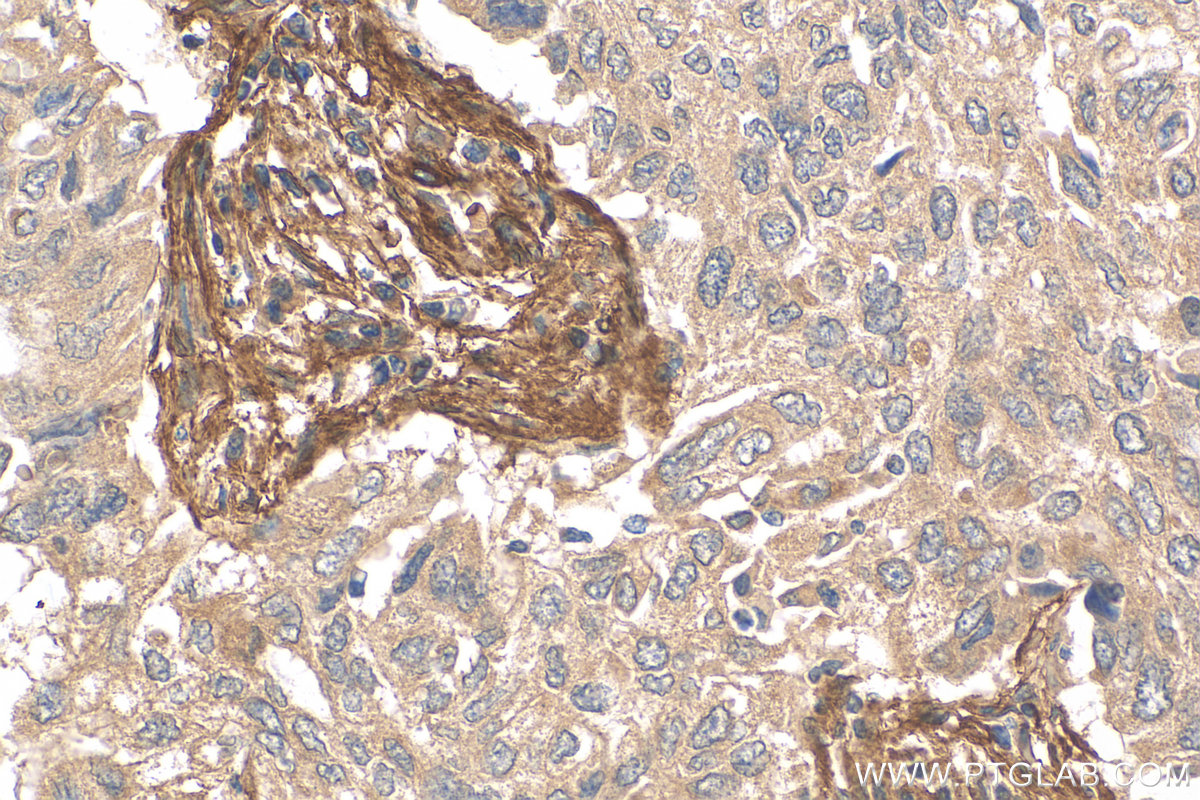

验证数据展示
经过测试的应用
| Positive WB detected in | pig brain tissue, mouse brain tissue, rat brain tissue |
| Positive IHC detected in | human colon cancer tissue, human lung cancer tissue, mouse spleen tissue, mouse brain tissue Note: suggested antigen retrieval with TE buffer pH 9.0; (*) Alternatively, antigen retrieval may be performed with citrate buffer pH 6.0 |
推荐稀释比
| 应用 | 推荐稀释比 |
|---|---|
| Western Blot (WB) | WB : 1:2000-1:10000 |
| Immunohistochemistry (IHC) | IHC : 1:50-1:500 |
| It is recommended that this reagent should be titrated in each testing system to obtain optimal results. | |
| Sample-dependent, Check data in validation data gallery. | |
发表文章中的应用
| IF | See 11 publications below |
产品信息
27178-1-AP targets CD90 in WB, IHC, IF, ELISA applications and shows reactivity with human, mouse, rat, pig samples.
| 经测试应用 | WB, IHC, ELISA Application Description |
| 文献引用应用 | IF |
| 经测试反应性 | human, mouse, rat, pig |
| 文献引用反应性 | human, mouse, rat |
| 免疫原 |
CatNo: Ag25603 Product name: Recombinant human CD90 protein Source: e coli.-derived, PGEX-4T Tag: GST Domain: 20-80 aa of BC065559 Sequence: QKVTSLTACLVDQSLRLDCRHENTSSSPIQYEFSLTRETKKHVLFGTVGVPEHTYRSRTNF 种属同源性预测 |
| 宿主/亚型 | Rabbit / IgG |
| 抗体类别 | Polyclonal |
| 产品类型 | Antibody |
| 全称 | Thy-1 cell surface antigen |
| 别名 | CD90 / Thy1, THY1, Thy 1 antigen, Thy 1 cell surface antigen, Thy 1 membrane glycoprotein |
| 计算分子量 | 161 aa, 18 kDa |
| 观测分子量 | 26 kDa |
| GenBank蛋白编号 | BC065559 |
| 基因名称 | CD90/Thy1 |
| Gene ID (NCBI) | 7070 |
| RRID | AB_3085933 |
| 偶联类型 | Unconjugated |
| 形式 | Liquid |
| 纯化方式 | Antigen affinity purification |
| UNIPROT ID | P04216 |
| 储存缓冲液 | PBS with 0.02% sodium azide and 50% glycerol, pH 7.3. |
| 储存条件 | Store at -20°C. Stable for one year after shipment. Aliquoting is unnecessary for -20oC storage. |
背景介绍
CD90, also known as THY1, is a 25-35 kD protein that is expressed on 1-4% of human fetal liver cells, cord blood cells, and bone marrow cells. CD90 is one of the essential surface molecules expressed on human MSC from bone marrow and other sources. Activation of Thy-1 has been reported to promote T cell activation. It also affects numerous nonimmunologic biological processes, including cellular adhesion, neurite outgrowth, tumor growth, migration, and cell death.
实验方案
| Product Specific Protocols | |
|---|---|
| IHC protocol for CD90 antibody 27178-1-AP | Download protocol |
| WB protocol for CD90 antibody 27178-1-AP | Download protocol |
| Standard Protocols | |
|---|---|
| Click here to view our Standard Protocols |
发表文章
| Species | Application | Title |
|---|---|---|
Bioact Mater Mechanism and regulatory strategy study on promoting vascularized bone regeneration via intracellular zinc ion transport | ||
Nat Commun Injectable ECM-mimetic dynamic hydrogels abolish ferroptosis-induced post-discectomy herniation through delivering nucleus pulposus progenitor cell-derived exosomes | ||
J Orthop Translat Osteostaticytes: A novel osteoclast subset couples bone resorption and bone formation | ||
Stem Cells Nicotinamide riboside modulates HIF-1 signaling to maintain and enhance odontoblastic differentiation in human dental pulp stem cells | ||
Transl Oncol A machine learning-based prognostic signature utilizing MSC proteomics for predicting bladder cancer prognosis and treatment response | ||
Neurogastroenterol Motil Construction and identification of an immortalized rat intestinal smooth muscle cell line. |